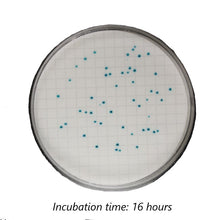
Load image into Gallery viewer, Colichrome® MF Coliform - 10 Pack (100 Tests)
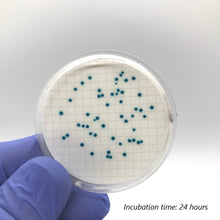
Load image into Gallery viewer, Colichrome® MF Coliform - 10 Pack (100 Tests)

Compared to other current testing methods, Colichrome® MF Coliform offers rapid testing with incredibly clear and easy-to-read results. Not only is Colichrome® MF Coliform capable of detecting the presence of Coliform, you can also determine the number of colonies. (NOTE: If the sample contains Aeromonas spp., they may give a similar appearance to the true coliform).
- Extremely accurate and easy to understand results
- Results in as little as 24 hours
- 1 bottle has enough media for 10 tests
- Coliform will show up as green/teal dots
How It Works
Colichrome® MF Coliform works similar to other membrane filter (MF) media, following the standard methodology using a membrane filtration device
However, unlike other testing methods where results are difficult to read and understand, Colichrome® MF Coliform results are clear and precise. After incubating your sample for 24-48 hours at 35° C, Coliform colonies will appear as green/teal dots. The dots will continue to grow in size and intensity up to 36-48 hours.
To enumerate, simply count the number of visible colonies (CFUs). For more detailed documentation and instructions, please see the PDFs below. Remember, we offer free technical support on any stage of the process and would be happy to instruct and advise you.
Technical Step-by-Step Instructions: View PDF document
Additional Helpful and Important Information
Why Colichrome® MF Coliform is Better Than Competing Products
Colichrome® MF Coliform has two revolutionary benefits over current testing products. First, the results from using Colichrome® MF Coliform are incredibly precise and easy to read. Simply count the number of green/teal dots after 24-48 hours of incubation at 35° C.
This increase in usability and accuracy doesn’t sacrifice speed. Colichrome® MF Coliform results are readable in as little as 24 hours, faster than most other testing products on the market.
Additional Equipment Needed
Colichrome® MF Coliform is a membrane filtration medium that requires the standard equipment for any membrane filtration process. If you’re looking for a method of detecting Coliform, but do not have the standard equipment, you might be more interested in our self-contained R-CARD® testing method that requires minimal additional equipment.
- Sterile pipettes
- Petri dishes
- Membranes Filters
- Vacuum pump or equivalent
- Forceps
- Microscope
- Incubator
Ideal Uses
- Food & Beverage
- Agriculture
- Education
- Municipal & Environmental Water
- Pharmaceuticals
- Veterinary
Why Choose Roth Biosciences?
Dr. Jonathan Roth is one of the most well-known names in microbiology and bacteria testing. He was the first to develop testing methods to use enzyme substrates for producing different colors to distinguish different types of bacteria. Roth Biosciences continues to offer some of the most revolutionary innovations in the industry.